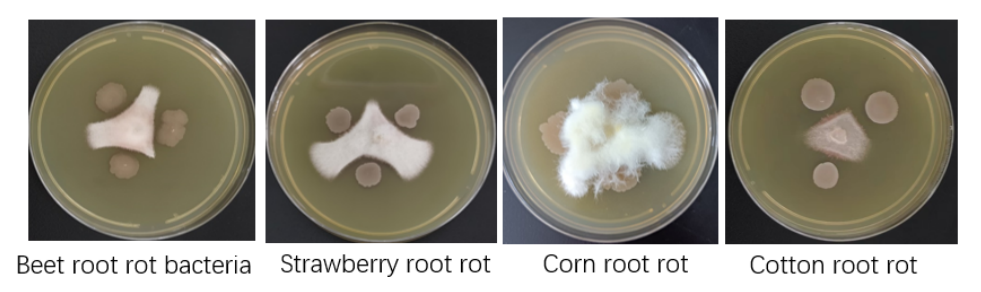

Bacillus subtilis, a Gram-positive bacterium, emerges as a powerhouse in rhizosphere growth promotion. Abundantly present in soil and decomposed organic matter, this resilient bacterium thrives even in arid grasslands. Furthermore, Bacillus subtilis establishes itself as a common endophytic bacteria in plants, exhibiting rapid reproduction and the generation of a plethora of essential metabolic substances, making it a staple in modern agriculture.
In adverse conditions such as challenging growth environments and nutrient deficiencies, Bacillus subtilis enters a spore dormancy period. During this phase, it forms highly resistant spores capable of enduring extreme polar conditions, including high temperatures and acidic or alkaline environments, showcasing its remarkable adaptability.
Enter Bacillus subtilis TC-4, a strain derived from the beetroot sphere cultivated in saline and repeatedly cropped plots in Inner Mongolia. Rigorously identified as a subspecies of Bacillus subtilis through morphological, physiological, biochemical, and molecular biology analyses, TC-4 stands out for its exceptional characteristics.
TC-4 stands as a prolific producer of growth-promoting biomass, including IAA, GA, BR, and more, exerting a remarkable impact on plant development. Notably, TC-4 harbors a multitude of nitrogen-fixing genes, surpassing market competitors in nitrogen-fixing efficacy. With over 80 genes dedicated to synthesizing diverse antibacterial bioactive substances, TC-4's antifungal prowess has been validated through plate face-off experiments against pathogenic bacteria.
In summary, the TC-4 strain, enriched with an extensive enzyme system and demonstrating saline-alkali resistance, not only possesses comparable antibacterial potential but also outshines renowned competitors in nitrogen-fixing capabilities. Its versatile applications span plant protection, aquatic products, and animal protection fields, making Bacillus subtilis TC-4 a game-changer in modern agriculture.
| Published by Zhou Can Engineer of Plant Nutrition Division |
The yeast source organic fertilizer has the advantages of being nutritional, efficient, environmental friendly, soil-improving, etc., and it is suitable for the application of high added value agricultural products, animal husbandry and economic crops. Angel is the founder of yeast source organic fertilizer, and the products all have passed through the EU Organic Certification and China Organic Certification.
About Angel:
Angel Yeast Company is a high-tech listed company specializing in yeast and biotech. Product business covers Yeast and Baking, Yeast Extract-Savoury, Nutrition & Health and Biotechnology fields. It is one of the world's leading companies in the yeast industry. Angel has 12 holding subsidiaries and provides products and services for more than 150 countries and regions.
Press Contact:
ANGEL YEAST CO., LTD
Address: 168 Chengdong Avenue, Yichang, Hubei 443003, P. R.China
Tel& Fax: +86-717-6371118
Email: weiqz@angelyeast.com







